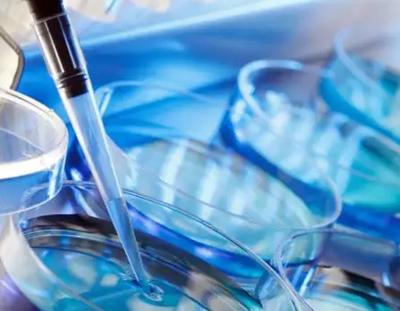
2022美国CDC比较新试管成功率大揭秘，38-40岁试管成功率一览

2022美国CDC比较新试管成功率大揭秘,38-40岁试管成功率一览
更新时间:2023-10-27
2022美国CDC比较新试管成功率大揭秘,38-40岁试管成功率一览,试管手术是一种比较先进的助孕技术,在手术中,医生会将女性的卵子和助孕进行助孕怀孕,然后在植入到宫腔里,而现阶段,国外的试管技术比较成熟,但其成功率却是因人而异的,下面我们就来说说2022美国CDC38-40岁女性做试管的成功率这一问题吧!
本表按周期总数排名,取2021年美国前20家诊所(共464家),周期为2094-9413家。对我们做试管的家长来说,有意义的数据是:H周期活产率列,成功率范围2.2%-22.9%的周期活产率为22.9%可以简单理解为平均1000个周期,229个孩子出生。
助孕括医院机构在内的医院和诊所通常是宣传成功率I列(首位紫色)移植妊娠率,范围27.9%-60.移植妊娠率为60%.9%可以简单理解为平均移植1000次,孕囊和胎心可以检测609次。E-I比较后四列代表新鲜胚胎周期(J,K,L,M)代表冷冻胚胎移植周期。
| 冻胚移植 | 成功率 | |
| ||
移植妊娠率为 | 19.4%-65.5% | |
| 冻胚移植妊娠率 | 43.9%-74.6% | |
| 冻胚移植活产率 | 33.3%-65.7% |
本表按38-40岁新鲜胚胎周期总数降序排名,取2021年加州前21家诊所,周期为35-272例。H周期率范围为3.5%-30.移植妊娠率8%,范围19%.4%-65.5%如果只关注冷冻胚胎移植呢?-看看加州69家诊所,前20名。
本表按38-40岁冷冻胚胎周期总数排名,取2021年加州前20家诊所,周期49-198例。冷冻胚胎移植妊娠率43.9%-74.6%冻胚移植活产率33.3%-65.7%。
小提示:这些数据来自美国官方机构,助孕括美国私人诊所,助孕括克利夫兰医学试管医院、哈佛试管医院麻省理工学院、约翰霍普金斯等高端医院,希望你了解助孕怀孕的成功率,不容易被愚弄,世界上无论国内、俄罗斯、乌克兰或泰国,都不能完全超过成功率水平,试管不容易,我们珍惜。
总而言之,不同医院做试管的成功率是不同的,根据上述的2022美国CDC比较新试管成功率来看,很多数据会有一些差异,因此在选择做试管的时候,患者也要根据自身情况来判断,以免影响到试管手术。
以上就是医院招聘网小编为大家整理的《2022美国CDC比较新试管成功率大揭秘,38-40岁试管成功率一览》相关信息,希望大家喜欢。
内容版权声明:本网站部分内容由网上整理转发,如有侵权请联系管理员进行删除.